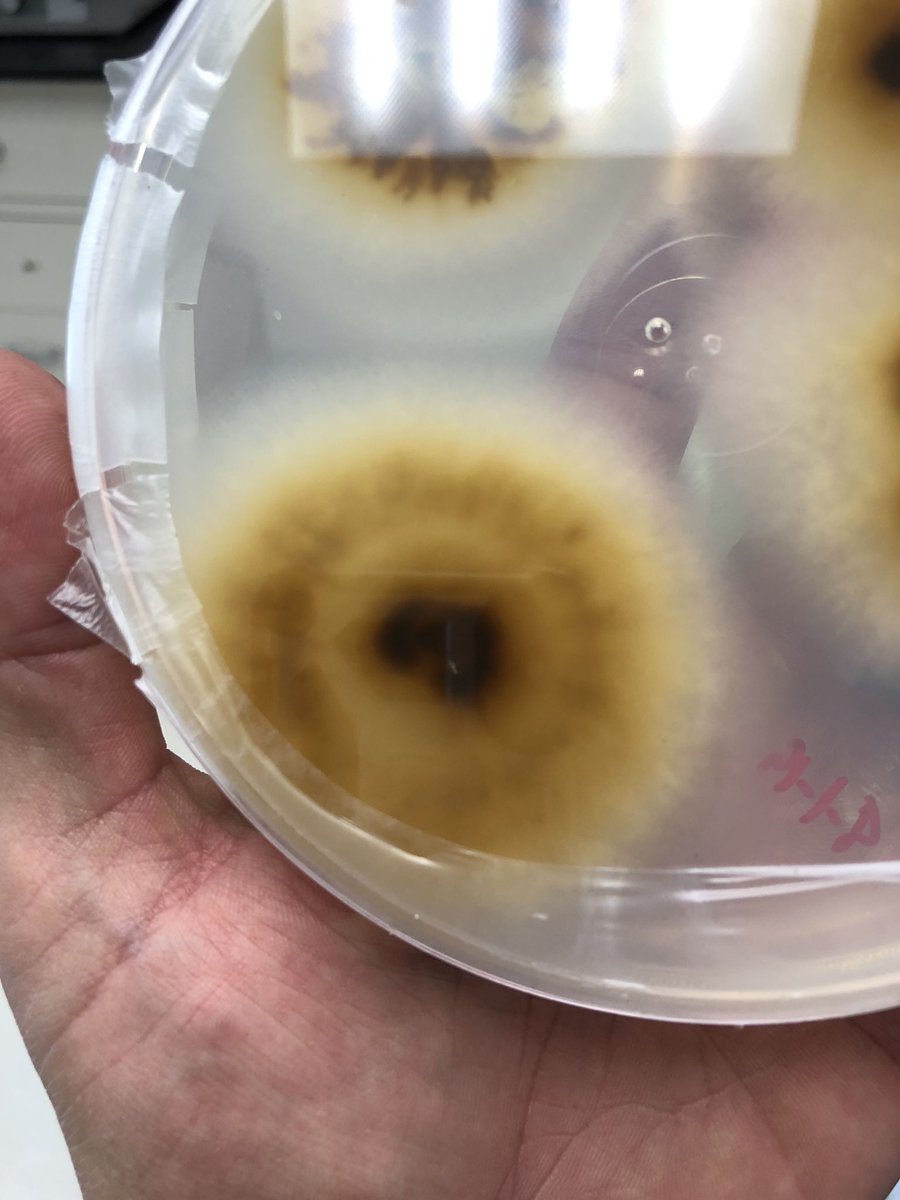
thebuffsciguy's tweet image. Culturing plant pathogens in the lab this week #planpathology #scienceinthelab #isolation #colletotrichum

#scienceinthelab search results
Culturing plant pathogens in the lab this week #planpathology #scienceinthelab #isolation #colletotrichum


Can Mice Reveal the SECRET of Fatigue? #AnimalResearch #FatigueStudy #ScienceInTheLab #MiceStudies #HealthResearch #MedicalScience #LaboratoryLife #AnimalTestingEthics #ScientificDiscovery #ResearchInnovation
10X2 nailed it in today's electrolysis practical! ⚡🔬 Pupils split sodium chloride & copper chloride solutions, watching elements emerge at the electrodes. 🧪✨ Real chemistry magic in action! #Electrolysis #STEMLearning #ScienceInTheLab


He's performing porewater electrical conductivity, alkalinity, pH, and major cation analysis - all key procedures to see a weathering signal. This helps us understand how rocks interact with their environment. ⚖️🔍 #ScienceInTheLab #ClimateSolutions
Loving the tracks that I am working on at the moment :-D #scienceinthelab
10X2 nailed it in today's electrolysis practical! ⚡🔬 Pupils split sodium chloride & copper chloride solutions, watching elements emerge at the electrodes. 🧪✨ Real chemistry magic in action! #Electrolysis #STEMLearning #ScienceInTheLab


Can Mice Reveal the SECRET of Fatigue? #AnimalResearch #FatigueStudy #ScienceInTheLab #MiceStudies #HealthResearch #MedicalScience #LaboratoryLife #AnimalTestingEthics #ScientificDiscovery #ResearchInnovation
He's performing porewater electrical conductivity, alkalinity, pH, and major cation analysis - all key procedures to see a weathering signal. This helps us understand how rocks interact with their environment. ⚖️🔍 #ScienceInTheLab #ClimateSolutions
Culturing plant pathogens in the lab this week #planpathology #scienceinthelab #isolation #colletotrichum


Loving the tracks that I am working on at the moment :-D #scienceinthelab
Culturing plant pathogens in the lab this week #planpathology #scienceinthelab #isolation #colletotrichum

10X2 nailed it in today's electrolysis practical! ⚡🔬 Pupils split sodium chloride & copper chloride solutions, watching elements emerge at the electrodes. 🧪✨ Real chemistry magic in action! #Electrolysis #STEMLearning #ScienceInTheLab


Something went wrong.
Something went wrong.
United States Trends
- 1. Everton 135K posts
- 2. GeForce Season 3,334 posts
- 3. Comey 168K posts
- 4. Amorim 56.5K posts
- 5. Manchester United 80.5K posts
- 6. Mark Kelly 109K posts
- 7. Seton Hall 2,137 posts
- 8. Pickford 10.4K posts
- 9. Opus 4.5 7,901 posts
- 10. #MUNEVE 15.4K posts
- 11. UCMJ 16.6K posts
- 12. #MUFC 23.6K posts
- 13. Dorgu 20.3K posts
- 14. Hegseth 42K posts
- 15. Benedict Arnold 3,389 posts
- 16. Man U 21.8K posts
- 17. Zirkzee 22.7K posts
- 18. #OTGala10 111K posts
- 19. Halligan 52.2K posts
- 20. Happy Thanksgiving 15.8K posts







